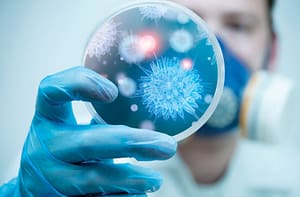
Pautas básicas

Pautas Básicas de Calidad y Bioseguridad en el Laboratorio de Análisis Clínicos
El presente trabajo nació en el seno de CUBRA, entre el Comité Ejecutivo y el aporte de Entidades Bioquímicas Provinciales de todo el País, sumando la activa participación de las Instituciones nacionales representativas y comprometidas con nuestra profesión.
Guía de sugerencias y/o recomendaciones para la Mejora Continua de la Calidad en Laboratorios de Análisis Clínicos de la República Argentina
Confederación Unificada Argentina de la República Argentina
Comisión de Calidad de C.U.B.R.A. – C3
El presente trabajo nació en el seno de CUBRA, entre el Comité Ejecutivo y el aporte de Entidades Bioquímicas Provinciales de todo el País, sumando la activa participación de las Instituciones nacionales representativas y comprometidas con nuestra profesión.
Esperamos continuar aportando en este sentido, tratando de brindar todo el apoyo necesario para que nuestro sector en su conjunto pueda avanzar permanentemente por un camino de distinción, a través de un proceso de mejora continua de la calidad y en la armonización de los procesos de toda nuestra red de prestadores, con quienes aseguramos ofrecer un mejor servicio en todo el ámbito nacional, a través de la continua búsqueda de la excelencia de la prestación bioquímica y cubriendo cada rincón de nuestro país.
Finalmente, nuestro más sincero agradecimiento en este emprendimiento conjunto, por todo el esfuerzo personal de quienes trabajan desinteresadamente, por el apoyo puesto de manifiesto desde las Instituciones adheridas a nuestra confederación, con la invalorable e incondicional asistencia y colaboración de CaSa – Calidad en Salud y de la FBA – Fundación Bioquímica Argentina.
Lic. Jorge Ricardo Alegre















